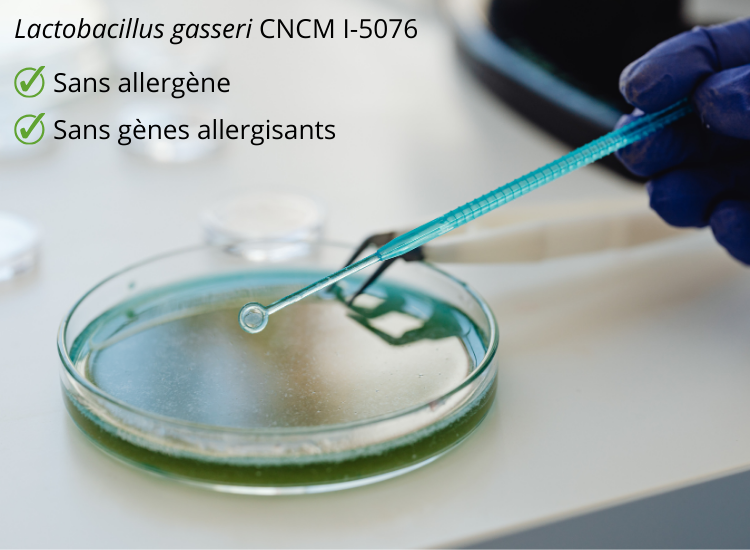

- EQUILIBRE DU POIDS*
- Extrait de café vert, standardisé à 45% d'acides chlorogéniques.
- Extrait de Rhodiola rosea standardisé à 5% de rosavines et 2% de salidrosides.
- Extrait de thé vert standardisé à 70% de polyphénols, qui stimule la perte de graisse et aide à réduire le poids corporel.
- Extrait de framboises standardisé en cétones.
- Action complémentaire de l'acétyl-L-tyrosine.
Complexe synergique pour l'équilibre et la réduction du poids.
Extraits naturels concentrés : café vert, Rhodiola rosea, acétyl-L-tyrosine, cétones de framboises, polyphénols de thé vert.
ÉQUILIBRE DU POIDS
Conditionnement :
60 gélules